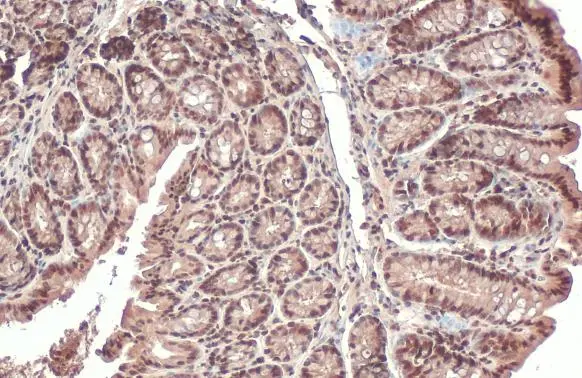
PPP1A antibody detects PPP1A protein at cytoplasm and nucleus by immunohistochemical analysis. Sample: Paraffin-embedded mouse colon. PPP1A stained by PPP1A antibody (GTX105255) diluted at 1:165. Antigen Retrieval: Citrate buffer, pH 6.0, 15 min

Various tissue extracts (30 μg) were separated by 10% SDS-PAGE, and the membrane was blotted with PPP1A antibody (GTX105255) diluted at 1:500.
PPP1A antibody
GTX105255
ApplicationsImmunoFluorescence, ImmunoPrecipitation, Western Blot, ImmunoCytoChemistry, ImmunoHistoChemistry, ImmunoHistoChemistry Paraffin
Product group Antibodies
ReactivityHuman, Mouse, Rat, Zebra Fish
TargetPPP1CA
Overview
- SupplierGeneTex
- Product NamePPP1A antibody
- Delivery Days Customer9
- Application Supplier NoteWB: 1:500-1:3000. ICC/IF: 1:100-1:1000. IHC-P: 1:100-1:1000. *Optimal dilutions/concentrations should be determined by the researcher.Not tested in other applications.
- ApplicationsImmunoFluorescence, ImmunoPrecipitation, Western Blot, ImmunoCytoChemistry, ImmunoHistoChemistry, ImmunoHistoChemistry Paraffin
- CertificationResearch Use Only
- ClonalityPolyclonal
- Concentration0.4 mg/ml
- ConjugateUnconjugated
- Gene ID5499
- Target namePPP1CA
- Target descriptionprotein phosphatase 1 catalytic subunit alpha
- Target synonymsPP-1A, PP1A, PP1alpha, PPP1A, serine/threonine-protein phosphatase PP1-alpha catalytic subunit, protein phosphatase 1, catalytic subunit, alpha isozyme, serine/threonine protein phosphatase PP1-alpha 1 catalytic subunit, testicular tissue protein Li 155
- HostRabbit
- IsotypeIgG
- Protein IDP62136
- Protein NameSerine/threonine-protein phosphatase PP1-alpha catalytic subunit
- Scientific DescriptionThe protein encoded by this gene is one of the three catalytic subunits of protein phosphatase 1 (PP1). PP1 is a serine/threonine specific protein phosphatase known to be involved in the regulation of a variety of cellular processes, such as cell division, glycogen metabolism, muscle contractility, protein synthesis, and HIV-1 viral transcription. Increased PP1 activity has been observed in the end stage of heart failure. Studies in both human and mice suggest that PP1 is an important regulator of cardiac function. Mouse studies also suggest that PP1 functions as a suppressor of learning and memory. Three alternatively spliced transcript variants encoding different isoforms have been found for this gene. [provided by RefSeq]
- ReactivityHuman, Mouse, Rat, Zebra Fish
- Storage Instruction-20°C or -80°C,2°C to 8°C
- UNSPSC41116161

![Non-transfected (–) and transfected (+) 293T whole cell extracts were separated by 10% SDS-PAGE, and the membrane was blotted with PPP1A antibody [HL1677] (GTX637276) diluted at 1:1000. The HRP-conjugated anti-rabbit IgG antibody (GTX213110-01) was used to detect the primary antibody, and the signal was developed with Trident ECL plus-Enhanced.](https://www.genetex.com/upload/website/prouct_img/normal/GTX637276/GTX637276_T-44760_20221209_WB_multiple_B_22121123_799.webp)
